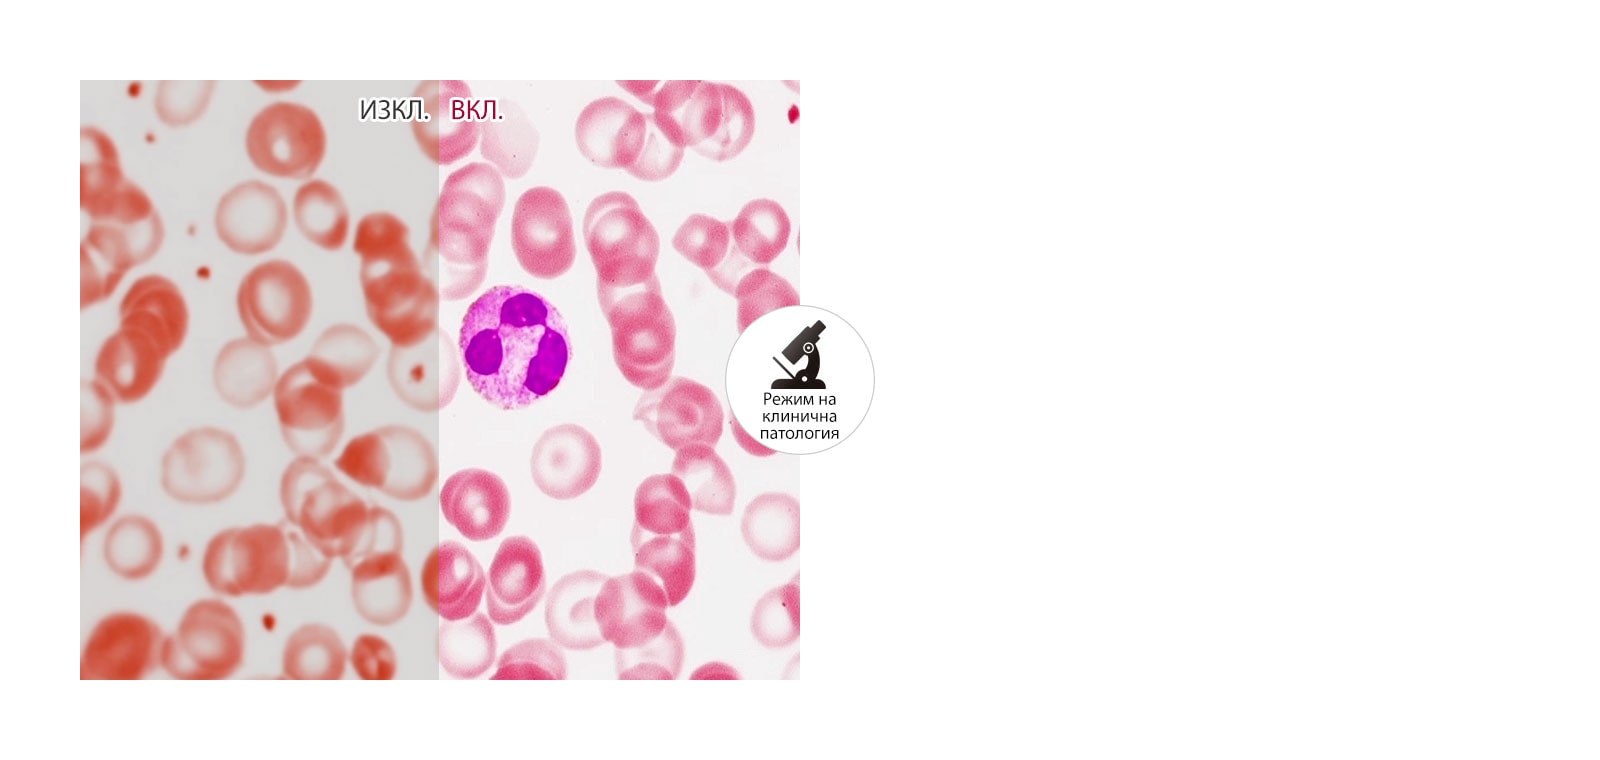
Реалистично възпроизвеждане на цветове

ДОБАВЯНЕ КЪМ СПИСЪКА С ЖЕЛАНИ ПРОДУКТИ
Добавяйте артикули към списъка си с желани продукти в MYLG
Вижте списъка с желани продуктиcomponent-OBScountrySelectDesc
*titleText*
Продажба с ограничено количество
-
Цена на продукта(32HL512D-M)
$*rPrice*$*rPromoPrice**discountPDPMsg*Цена за членове на LG(32HL512D-M)$*rMemberPrice*$*rMembershipPrice**discountPDPMsg*vip-price-message(32HL512D-M)$*rPrice*$*rVipPrice**discountPDPMsg*OBS_CHEAPERPRICE_MSG $*cheaperPrice*
Цена за членове на LG$*rMembershipPrice**rWelcomePriceDescription**rWelcomePriceTooltip*
$*rWelcomePrice*
OBS_MEMBERSHIP_MSG $*membershipPrice*
*obsMemberShipLinkEnd*OBS_LOWEST_PRICE_MARK_MSG
OBS_CHEAPERPRICE_MSG $*cheaperPrice*
OBS_MEMBERSHIP_MSG $*recommendedMembershipPrice*
bundle-unable-text
OBS_LOWEST_PRICE_MARK_MSG
OBS_LOWEST_PRICE_MARK_MSG


31,5-инчов 8MP диагностичен монитор


Прецизно изображение от всякакъв ъгъл


Съвместим с всяко устройство

Реалистично възпроизвеждане на цветове


Постоянно качество на картината


За по-голяма ефективност и
удобство


Множество сигнали на един екран


Разработен за удобство и потапяне
Гаранция на LG Electronics за повредени пиксели
1. Определение за цветни и тъмни пиксели
Панелът на LCD монитора се състои от милион червени, зелени и сини суб-пиксели, които визуализират цветовете на монитора, както е показано на картинка 1. Суб-пикселите представляват ярки или тъмни петна на екрана, Картинка 2, със следните отличителни характеристики:
1-1. Цветен суб-пиксел: Малко осветено петно на екрана в червено, зелено или синьо
1-2. Тъмен суб-пиксел: Малки тъмни, но добре видими петна на екрана
Тъмен или цветен суб-пиксел може да се появи по време на производството на LCD монитор, но това по никакъв начин не влияе на неговата функционалност. Повредените пиксели лесно могат да бъдат разпознати от потребителя след включване на монитора за работа. Повредените пиксели представляват малки петна сред течните кристали, които съставляват монитора. Не се счита за дефект цветен или тъмен пиксел, освен ако не надвишава допустимия праг за дефект, както е посочено в Таблица 1.
-
- Вид на панела
- 31.5"
- Вид на панела
- IPS
- Вид на панела
-
- Формат
- 16:9
- Резолюция
- 3840 x 2160
-
- Яркост (cd/m2)
- тип.: 450 cd/m2
- Контрастно съотношение (оригинално)
- тип.: 1300:1
-
- Време за реакция (GTG)
- 14ms (Off-setting), 5ms (Faster-setting)
- Зрителен ъгъл (контрастно съотношение≥10)
- 178º(R/L), 178º(U/D)
-
- Цветова гама
- DCI-P3 98%(CIE1976)
-
- D-Sub
- He
- DVI-D
- He
-
- HDMI
- да (1 ea)
- DisplayPort
- да (2 ea)
-
- Thunderbolt
- He
- Daisy Chain
- He
-
- Изход за слушалки
- Не
- USB Upstream Port
- да (1 ea/ver2.0)
-
- USB Downstream Port
- да (2 ea/ver2.0)
-
- Тип
- Външен източник на захранване (адаптер)
- Вход
- 100~240V (50/60Hz)
-
- Изход
- 19V, 3.42A
- DC изкл. (макс.)
- По-малко от 0.3W
-
- Hot Key
- He
- Multi-resolution Mode
- да (8MP/6MP/4MP)
-
- Flicker Safe (Защита от трептене)
- Да
- Black Stabilizer (Стабилизатор на черното)
- Да
-
- PIP
- He
- PBP
- Да (2PBP)
-
- Dual control
- Да
- HDR
- HDR10
-
- Режим на четене
- Да
- Супер резолюция +
- Да
-
- DICOM Mode
- да
- On Screen Control
- He
-
- микрофон
- He
- Камера
- He
-
- Интелигентно пестене на енергия
- да
- Хардуерно калибриране
- да (PerfectLum)
-
- Цветна слабост
- He
- Автоматична яркост
- He
-
- Сваляща се основа
- Да
- Накланяне (ъгъл)
- -5°~20˚
-
- Завъртане (ъгъл)
- He
- Височина (диапазон)
- 110 mm
-
- Ос (ъгъл)
- ±90°
-
- Комплект (със стойка)
- 718.2 x 590 x 231.2 mm
- Комплект (без стойка)
- 718.2 x 414.3 x 45.1 mm
-
- Кутия
- 838 x 553 x 240 mm
- Размер при стенен монтаж (mm)
- 100 x 100 mm
-
- Комплект (със стойка)
- 7 kg
- Комплект (без стойка)
- 5.6 kg
- Комплект (със стойка)
-
- Кутия<
- 11.4 kg
- Кутия<
-
- CE
- MDR
- UL (cUL)
- Да
-
- Други
- GMP, MP, RoHS, REACH, WEEE, MFDS
-
- Захранващ кабел
- Да
- D-Sub
- He
-
- DVI-D
- He
- HDMI
- Да
-
- Display Port
- да
- Adapter
- Да
-
- USB A to B
- He
- The safety information for accessories is included with the safety information for the product and is not provided separately.
- Информацията за безопасност на аксесоарите е включена в информацията за безопасност на продукта и не се предоставя отделно.
- За да научите повече за това как този продукт обработва данни и за вашите права като потребител, моля, посетете „Обхват и спецификации на данните“ на LG Privacy.
За да получите достъп до повече технически документи и възможности за изтегляне, моля, посетете Портал за LG B2B партньори
- продажби
- Инсталиране
- услуга
Няма резултати, които да отговарят на въведените критерии.
Моля, опитайте отново да въведете пощенския код.
OBS_MEMBERSHIP_MSG $*siblingMembershipPrice*
*obsMemberShipLinkEnd*

















